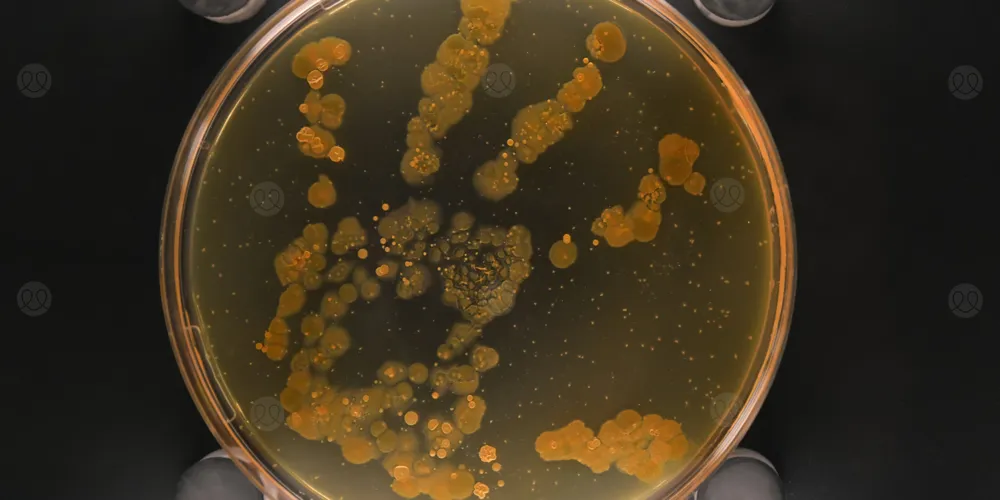
سلالة شائعة من

كشف فريق دولي من الباحثين أن إحدى السلالات الشائعة من الإشريكية القولونية (E. coli) قادرة على الانتقال بين البشر بالسرعة ذاتها التي تنتشر بها بعض الفيروسات، مثل فيروس إنفلونزا الخنازير (H1N1).
نُشرت نتائج الدراسة في مجلة Nature Communications، واعتمدت على بيانات من المملكة المتحدة والنرويج، حيث فحص العلماء 3 سلالات رئيسية من البكتيريا، اثنتان منها مقاومتان لعدة فئات من المضادات الحيوية، ويُعتقد أن هذا الإنجاز سيساعد بشكل كبير في مكافحة العدوى المقاومة للعلاجات والمضادات الحيوية مستقبلاً.
E. coli… بكتيريا شائعة بمخاطر مقلقة
تعيش الإشريكية القولونية بشكل طبيعي في الأمعاء، ولا تسبب مشاكل في معظم الأحيان، لكن دخولها إلى الجهاز البولي أو الدم قد يؤدي إلى عدوى خطيرة، خصوصاً لدى أصحاب المناعة الضعيفة.
تكمن خطورتها في قدرتها المتزايدة على مقاومة العلاج، ففي المملكة المتحدة وحدها، يُظهر أكثر من 40% من حالات عدوى "إي كولاي" في مجرى الدم مقاومة لأحد المضادات الحيوية الرئيسية.
اكتشاف جديد في سرعة انتشار البكتيريا
للمرة الأولى، تمكن الباحثون من حساب رقم التكاثر (R0) — وهو المؤشر الذي يوضح مدى سرعة انتشار العدوى.
هذا المؤشر يُستخدم عادة في متابعة تفشي الفيروسات، مثل كورونا و إنفلونزا الخنازير، ولم يكن ممكناً سابقاً تطبيقه على بكتيريا تعيش في الأمعاء، مثل "إي كولاي"، إلا أنه باسخدام منصة برمجية متطورة، وبيانات ضخمة من المملكة المتحدة والنرويج، نجح العلماء في تحقيق ذلك أخيرًا، مكتشفين حقائق جديدة وصاعقة لأول مرة.
النتائج
وجدت الدراسة نتائج متباينة ومهمة للغاية:
- السلالة سريعة الانتشار (ST131-A): اكتشف الباحثون أن هذه السلالة تحديداً يمكن أن تنتشر بسرعة هائلة تماثل سرعة فيروس إنفلونزا الخنازير، على الرغم من أن "إي كولاي" لا تنتقل عبر الرذاذ في الهواء (بل عبر التلامس المباشر أو غير المباشر).
- السلالات المقاوِمة (ST131-C1 و ST131-C2): هاتان السلالتان، وهما من أكثر السلالات مقاومة للمضادات الحيوية شيوعاً في بريطانيا والنرويج، أظهرتا سلوكاً مختلفاً. وجد الباحثون أنهما لا تنتشران بسرعة بين الأفراد الأصحاء في المجتمع لحسن الحظ.
- خطر المستشفيات: الأهم من ذلك، رجحت الدراسة أن السلالتين المقاومتين (C1 و C2) تمتلكان قابلية أعلى بكثير للانتقال داخل المستشفيات ومرافق الرعاية الصحية، مما يعني أنهما "بكتيريا خارقة" متخصصة في بيئات الرعاية الصحية، وليس خارجها.
مستقبل مواجهة مقاومة المضادات الحيوية
يمنح حساب سرعة تكاثر البكتيريا الخبراء فهماً أعمق للعوامل المؤثرة على انتقال العدوى، ويسمح لهم بتحديد السلالات ذات الخطورة الأعلى، وتوجيه تدابير الصحة العامة؛ لحماية الفئات الأكثر ضعفاً.
وقال البروفيسور يوكا كوراندر، كبير مؤلفي الدراسة من معهد سانجر وجامعة أوسلو: "الآن بعد أن أصبح بإمكاننا رؤية مدى سرعة انتشار بعض هذه السلالات البكتيرية، من الضروري فهم دوافعها الوراثية (الجينية)".
وأضاف: "فهم الجينات الوراثية لسلالات معينة يمكن أن يؤدي إلى طرق جديدة لتشخيص وعلاج هذه البكتيريا في أماكن الرعاية الصحية، وهو أمر بالغ الأهمية خاصة للبكتيريا المقاومة بالفعل لأنواع متعددة من المضادات الحيوية".
 تسجيل دخول
تسجيل دخول